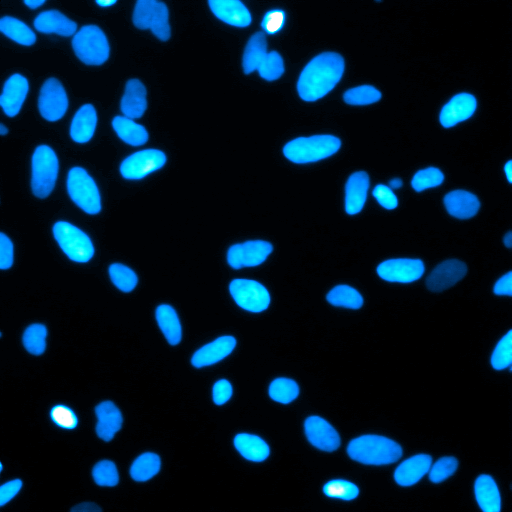
Segment After 1

We present FluoGen, a diffusion-based generative foundation model designed to improve the performance of AI-based methods in data-constrained fluorescence image processing.

We present FluoGen, a diffusion-based generative foundation model designed to improve the performance of AI-based methods in data-constrained fluorescence image processing.
Qualitative results of our FluoGen-s method. Drag the slider to compare the low-resolution input (Before) with the high-resolution output generated by FluoGen (After).








Qualitative results of our FluoGen-n method. Our method effectively removes noise while preserving fine structural details.
FluoGen generates realistic images from segmentation masks, serving as a powerful data augmentation tool for segmentation methods.

Large-scale, heterogeneous fluorescence microscopy dataset for generative pre-training. The scale and diversity of the dataset provide a robust foundation for learning generalizable representations of cellular organization.

Visual comparison of super-resolution results from FluoGen-s and other state-of-the-art methods on typical organelles (F-actin, microtubules, ER, and CCPs) from the BioSR dataset. Corresponding ground truth (GT) images are shown for reference.